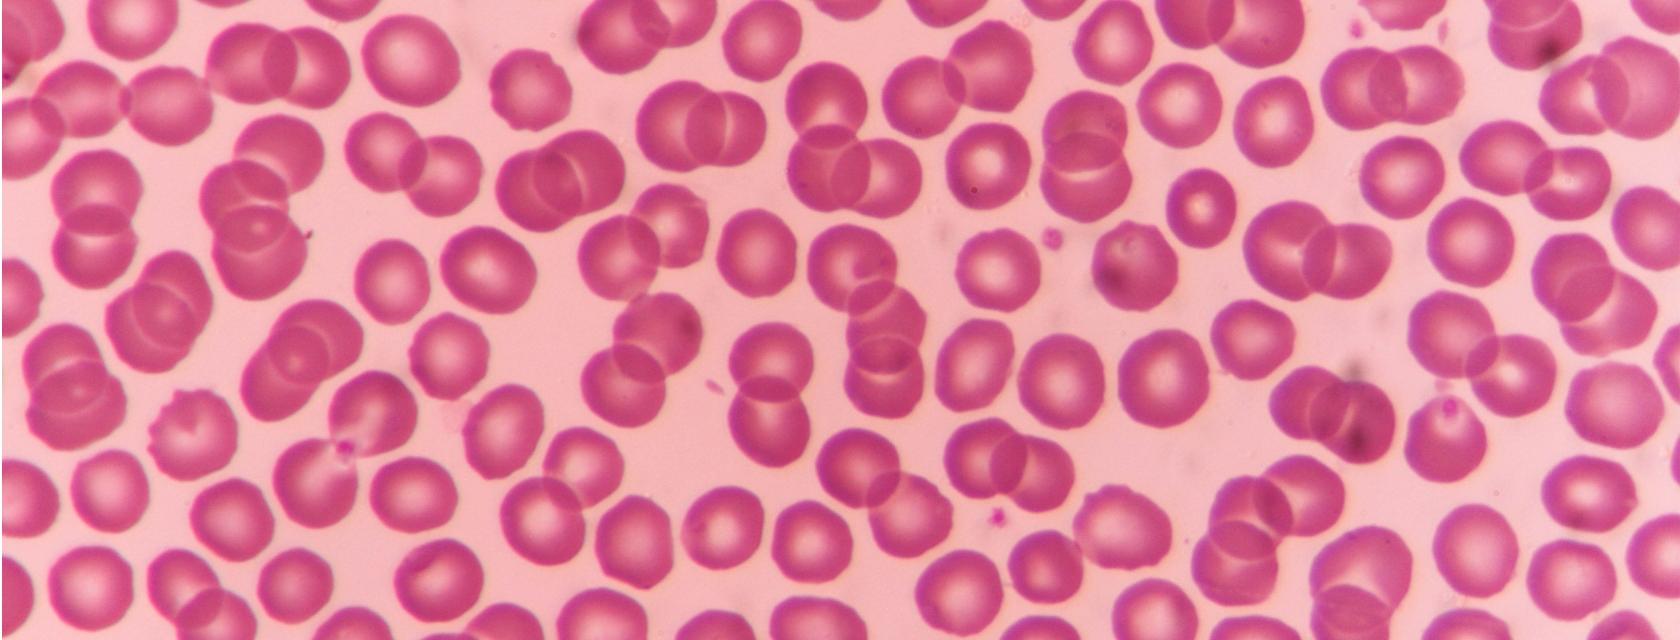
microscopic image of red blood cells

The College of Biological Science is a globally recognized academic faculty with a mission to expand the understanding of life, from DNA to cells to complex ecosystems. It produces intrepid and interdisciplinary research in a student-centred learning environment that encourages and promotes comprehensive understanding of the systems that govern life.